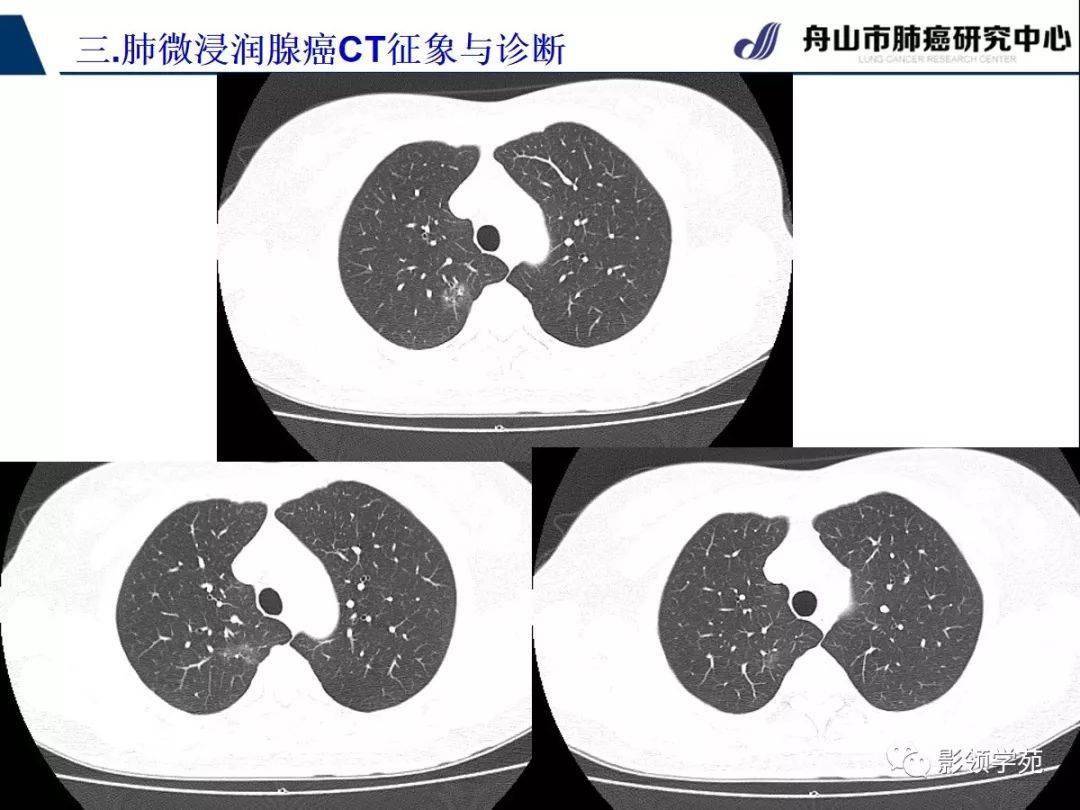
微浸润肺腺癌(mia)

微侵润腺癌

术后病理提示:微小浸润性腺癌,今年复查发现右上肺出现1
图片尺寸1080x810
腺癌(ais),微浸润腺癌(mia)一直到浸润性腺癌(iac)是一个自然发展过程
图片尺寸1525x1316
病理科工作札记四十二乳腺浸润性微乳头状癌
图片尺寸800x600
经典微浸润肺腺癌
图片尺寸1080x810
早期肺腺癌ct表现之微浸润肺腺癌
图片尺寸1200x900
早期肺腺癌ct表现之微浸润肺腺癌
图片尺寸1200x900
典型的磨玻璃微浸润腺癌,因磨玻璃结节夫妻俩问诊记(下)
图片尺寸640x429
微浸润腺癌,是癌也不是"癌"_肺癌_介绍_预后 - 好大夫在线
图片尺寸436x395
8mm磨玻璃结节微浸润性腺癌
图片尺寸1080x810
衡道丨干货肺腺癌的诊断体系2微浸润性肺腺癌
图片尺寸1080x516
早期肺癌之微浸润癌mia
图片尺寸484x871
早期肺腺癌ct表现之微浸润肺腺癌
图片尺寸1200x900
衡道丨干货肺腺癌的诊断体系2微浸润性肺腺癌
图片尺寸1080x650
经典微浸润肺腺癌
图片尺寸1080x810
早期肺腺癌ct表现之微浸润肺腺癌
图片尺寸1200x900
微浸润肺腺癌(mia)
图片尺寸1080x810
经典微浸润肺腺癌
图片尺寸1080x810
肺部磨玻璃阴影判断是肺原位癌或微浸润腺癌之所以重要_【吉康旅】
图片尺寸2478x2000
早期肺腺癌术后,病理报告浸润性腺癌,乳头型为主,需要基因检测吗?
图片尺寸1080x411
微浸润肺腺癌(mia)
图片尺寸1080x810